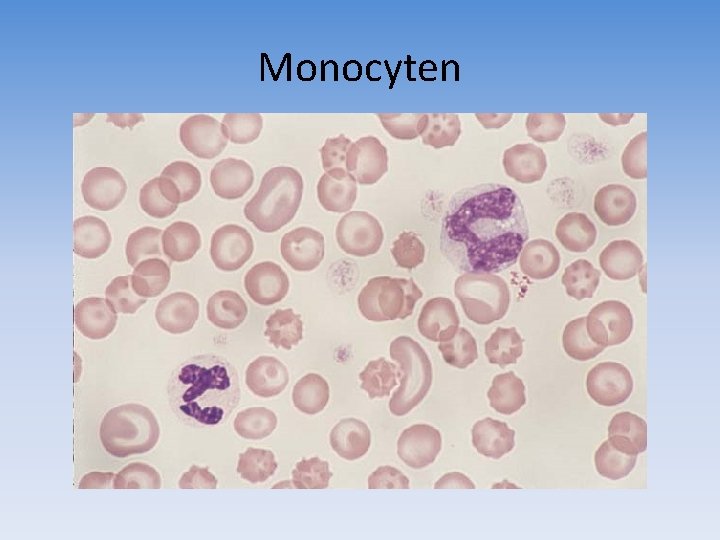
Monocyten

Bloedonderzoek De samenstelling van bloed Bloedplasma Water Eiwitten

Bloedonderzoek

De samenstelling van bloed • Bloedplasma: – Water – Eiwitten, zouten, voedingsstoffen, afbraakproducten, hormonen, stollingsfactoren • Cellen: – Erytrocyten (rode bloedcellen) – Leukocyten (witte bloedcellen) – Trombocyten (bloedplaatjes)

Onderzoek van bloed • Chemisch: Bloedplasma: – Water – Eiwitten, zouten, voedingsstoffen, afbraakproducten, hormonen, stollingsfactoren • Hematologisch: Cellen: – Erytrocyten (rode bloedcellen) – Leukocyten (witte bloedcellen) – Trombocyten (bloedplaatjes)

Bloedonderzoek Doel • Het lichaam probeert de samenstelling van het bloed zo constant mogelijk te houden (binnen normaal- / referentiewaarden) • • • Bloedsuikerspiegel Vochtgehalte Aantal erytrocyten Hoeveelheid afvalproducten Enz , enz • Het vaststellen van hematologische en chemische veranderingen van het bloed is van belang voor het opsporen en diagnostiseren van ziektes

Bloedafname Vena jugularis http: //provisioning. ontwikkelcentrum. nl/obje cts//OC-33071 -2 -23 d/OC-33071 -223 d. html Vena cephalica http: //provisioning. ontwikkelcentru m. nl/objects//OC-33071 -2 -24 d/OC 33071 -2 -24 d. html

Bloedafname http: //www. youtube. com/watch? v=ZEs. HM w. KFb. Kg

Hemolyse • • Lysis = oplossen Hemolyse = rbc’s gaan stuk Autogeen Iatrogeen

Preventie hemolyse • Schone eenmalige materialen • Bij voorkeur vacuümsysteem • Niet te dunne naalden • Niet schudden maar zwenken • Voldoende bloed in verhouding tot antistol • Niet overdreven lang stuwen • Geen verontreiniging

Bloedonderzoek • Afhankelijk van het gevraagde onderzoek en de gebruikte onderzoeksmethode: – Volbloed: onstolbaar gemaakt bloed – Plasma: vloeistof na centrifugeren van onstolbaar gemaakt bloed (bevat wel fibrinogeen) – Serum: vloeistof na centrifugeren van gestold bloed (bevat geen fibrinogeen)

Plasma of serum? plasma serum

Anticoagulantia • Antistollingsmiddelen: – Citraat (bezinking, stolling) – Oxalaat (enzymbepaling) – Natriumfluoride – EDTA (hematologisch bloedonderzoek) – Heparine (bepaling electrolyten, hematocriet) – Werking: reactie aangaan met calcium / trombine onwerkzaam maken blokkeren stolling

Bloedbuizen

Verzenden • • • Goed verpakt Gegevens dier + eigenaar Volledig ingevuld aanvraagformulier Gekoeld Zo snel mogelijk

Hematologisch bloedonderzoek Onderzoek naar de bloedcellen

Erytrocyten

Erytrocyten Functie • Erytrocyten bevatten hemoglobine • Hemoglobine is een ijzerhoudend eiwit dat zuurstof (O₂) en koolstofdioxide (CO₂) kan binden • Erytrocyten zorgen voor het transport van O₂ vanuit de longen richting de weefsels en voor het afvoeren van CO₂

Erytrocyten Aanmaak • Aanmaak erytrocyten in het beenmerg vanuit stamcellen • Bij verhoogde aanmaak zijn kernhoudende voorlopers (reticulocyten) in het bloed waar te nemen

Erytrocyten Afbraak • Beperkte levensduur: afhankelijk van de diersoort • Afbraak in de milt en de lever bilirubine • “Kapotgaan” van erytrocyten = hemolyse • Normaal is de aanmaak en afbraak van erytrocyten in evenwicht, zoniet. .

Bloedarmoede/anemie • Een te laag gehalte aan hemoglobine of een tekort aan circulerende erytrocyten, of beide • Oorzaken: – Bloedverlies – Verhoogde afbraak (hemolytische anemie) – Verminderde aanmaak – Voedingsfouten: ijzer- en/of vitaminetekort – Opnamestoornissen

Hemoglobine gehalte • • Hb gehalte Gram per 100 ml (g%) Mmol/l Spencer hemometer

Hematocriet • De hematocrietwaarde (Ht) is de waarde die de verhouding aangeeft tussen het volume van de erytrocyten in het bloed en het totale bloedvolume

Bepaling Ht

Bepaling Ht

Referentiewaarden Hb en Ht Diersoort Hemoglobine-gehalte Hematocriet Hond 8, 8 – 11, 7 mmol/l 0, 42 – 0, 57 Kat 5, 0 – 8, 1 mmol/l 0, 33 – 0, 46 Paard 7, 5 – 8, 7 mmol/l 0, 36 – 0, 42 Rund 6, 2 – 7, 5 mmol/l 0, 27 – 0, 36

Leukocyten Functie • Acute infectie verhoogde aanmaak van leukocyten in beenmerg en lymfeknopen (= leukocytose) naar plaats van infectie (amoeboïde beweging) fagocytose pus

Leukocytentelling • Een verhoogd aantal witte bloedcellen (leukocytose) is dus een aanwijzing voor een acute infectie • Telkamers

Leukocyten • Verschillende soorten: – Granulocyten: • Eosinofiele granulocyten • Basofiele granulocyten • Neutrofiele granulocyten – Staafkernig – Segmentkernig – Lymfocyten – Monocyten

Bloeduitstrijkje

Kleuring

Eosinofiele granulocyten

Basofiele granulocyten

Neutrofiele granulocyten Staafkernig / Segmentkernig

Lymfocyten
Monocyten

Trombocyten

Trombocyten Functie • Spelen een belangrijke rol bij de bloedstolling • Hechten zich aan de beschadigde bloedvatwand • Activeren (samen met o. a. calcium) de omzetting van fibrinogeen in fibrine

Chemisch bloedonderzoek

Chemisch bloedonderzoek Apparatuur

Chemisch bloedonderzoek Bepalingen • Ureum/creatinine: nieraandoening, uitdroging • AF/ALT/bilirubine/galzuren: leveraandoening • Albumine: lever-/nieraandoening, ondervoeding • Bloedglucose: diabetes • Elektrolyten (Na, K, Ca, Mg, Cl)

Ovucheck Premate

Snap Test Bloed en conjugaat pipetteren in cuvetje Mengsel aanbrengen in “Snapper”

Snap Test “Snapper “ indrukken zodra monster in werkingscirkel verschijnt Monster stroomt richting werkingscirkel

Snap Test Na 10 minuten resultaat aflezen Fe. LV en FIV negatief Fe. LV positief Fe. LV en FIV positief
- Slides: 43